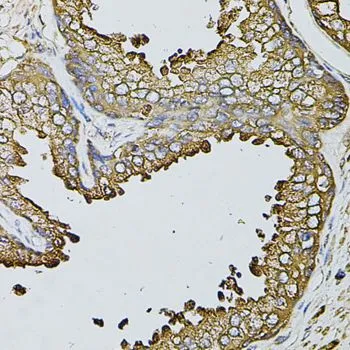

IHC-P analysis of human prostate tissue using GTX65975 Fast skeletal myosin light chain 1 antibody. Dilution : 1:100
Fast skeletal myosin light chain 1 antibody
GTX65975
ApplicationsWestern Blot, ImmunoHistoChemistry, ImmunoHistoChemistry Paraffin
Product group Antibodies
ReactivityHuman, Mouse, Rat
TargetMYL1
Overview
- SupplierGeneTex
- Product NameFast skeletal myosin light chain 1 antibody
- Delivery Days Customer9
- Application Supplier NoteWB: 1:500 - 1:2000. IHC-P: 1:50 - 1:200. *Optimal dilutions/concentrations should be determined by the researcher.Not tested in other applications.
- ApplicationsWestern Blot, ImmunoHistoChemistry, ImmunoHistoChemistry Paraffin
- CertificationResearch Use Only
- ClonalityPolyclonal
- ConjugateUnconjugated
- Gene ID4632
- Target nameMYL1
- Target descriptionmyosin light chain 1
- Target synonymsCMYO14, CMYP14, MLC-1, MLC1, MLC1/3, MLC1F, MLC3F, MYOFTA, myosin light chain 1/3, skeletal muscle isoform, A1 catalytic, A2 catalytic, MLC1/MLC3, MLC1F/MLC3F, myosin light chain A1/A2, myosin light chain alkali 1/2, myosin, light chain 1, alkali; skeletal, fast, myosin, light polypeptide 1, alkali; skeletal, fast
- HostRabbit
- IsotypeIgG
- Protein IDP05976
- Protein NameMyosin light chain 1/3, skeletal muscle isoform
- Scientific DescriptionMyosin is a hexameric ATPase cellular motor protein. It is composed of two heavy chains, two nonphosphorylatable alkali light chains, and two phosphorylatable regulatory light chains. This gene encodes a myosin alkali light chain expressed in fast skeletal muscle. Two transcript variants have been identified for this gene. [provided by RefSeq, Jul 2008]
- ReactivityHuman, Mouse, Rat
- Storage Instruction-20°C or -80°C,2°C to 8°C
- UNSPSC12352203







